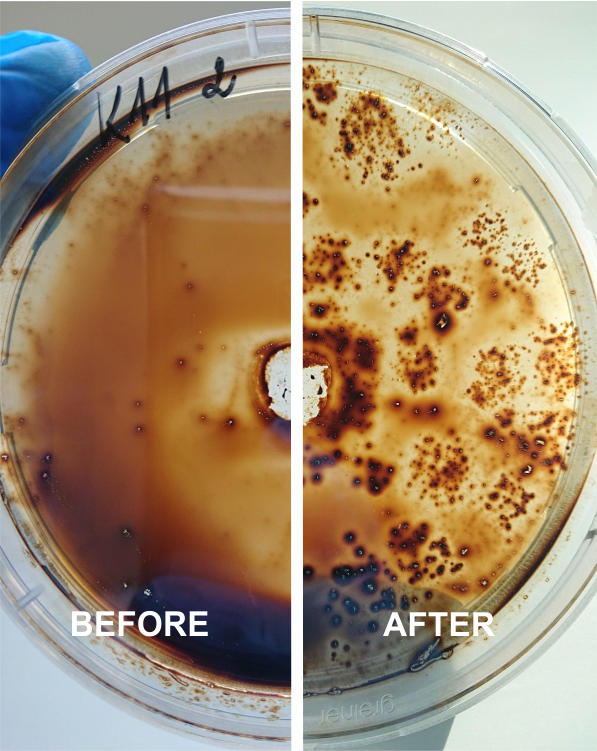
Biotechnology
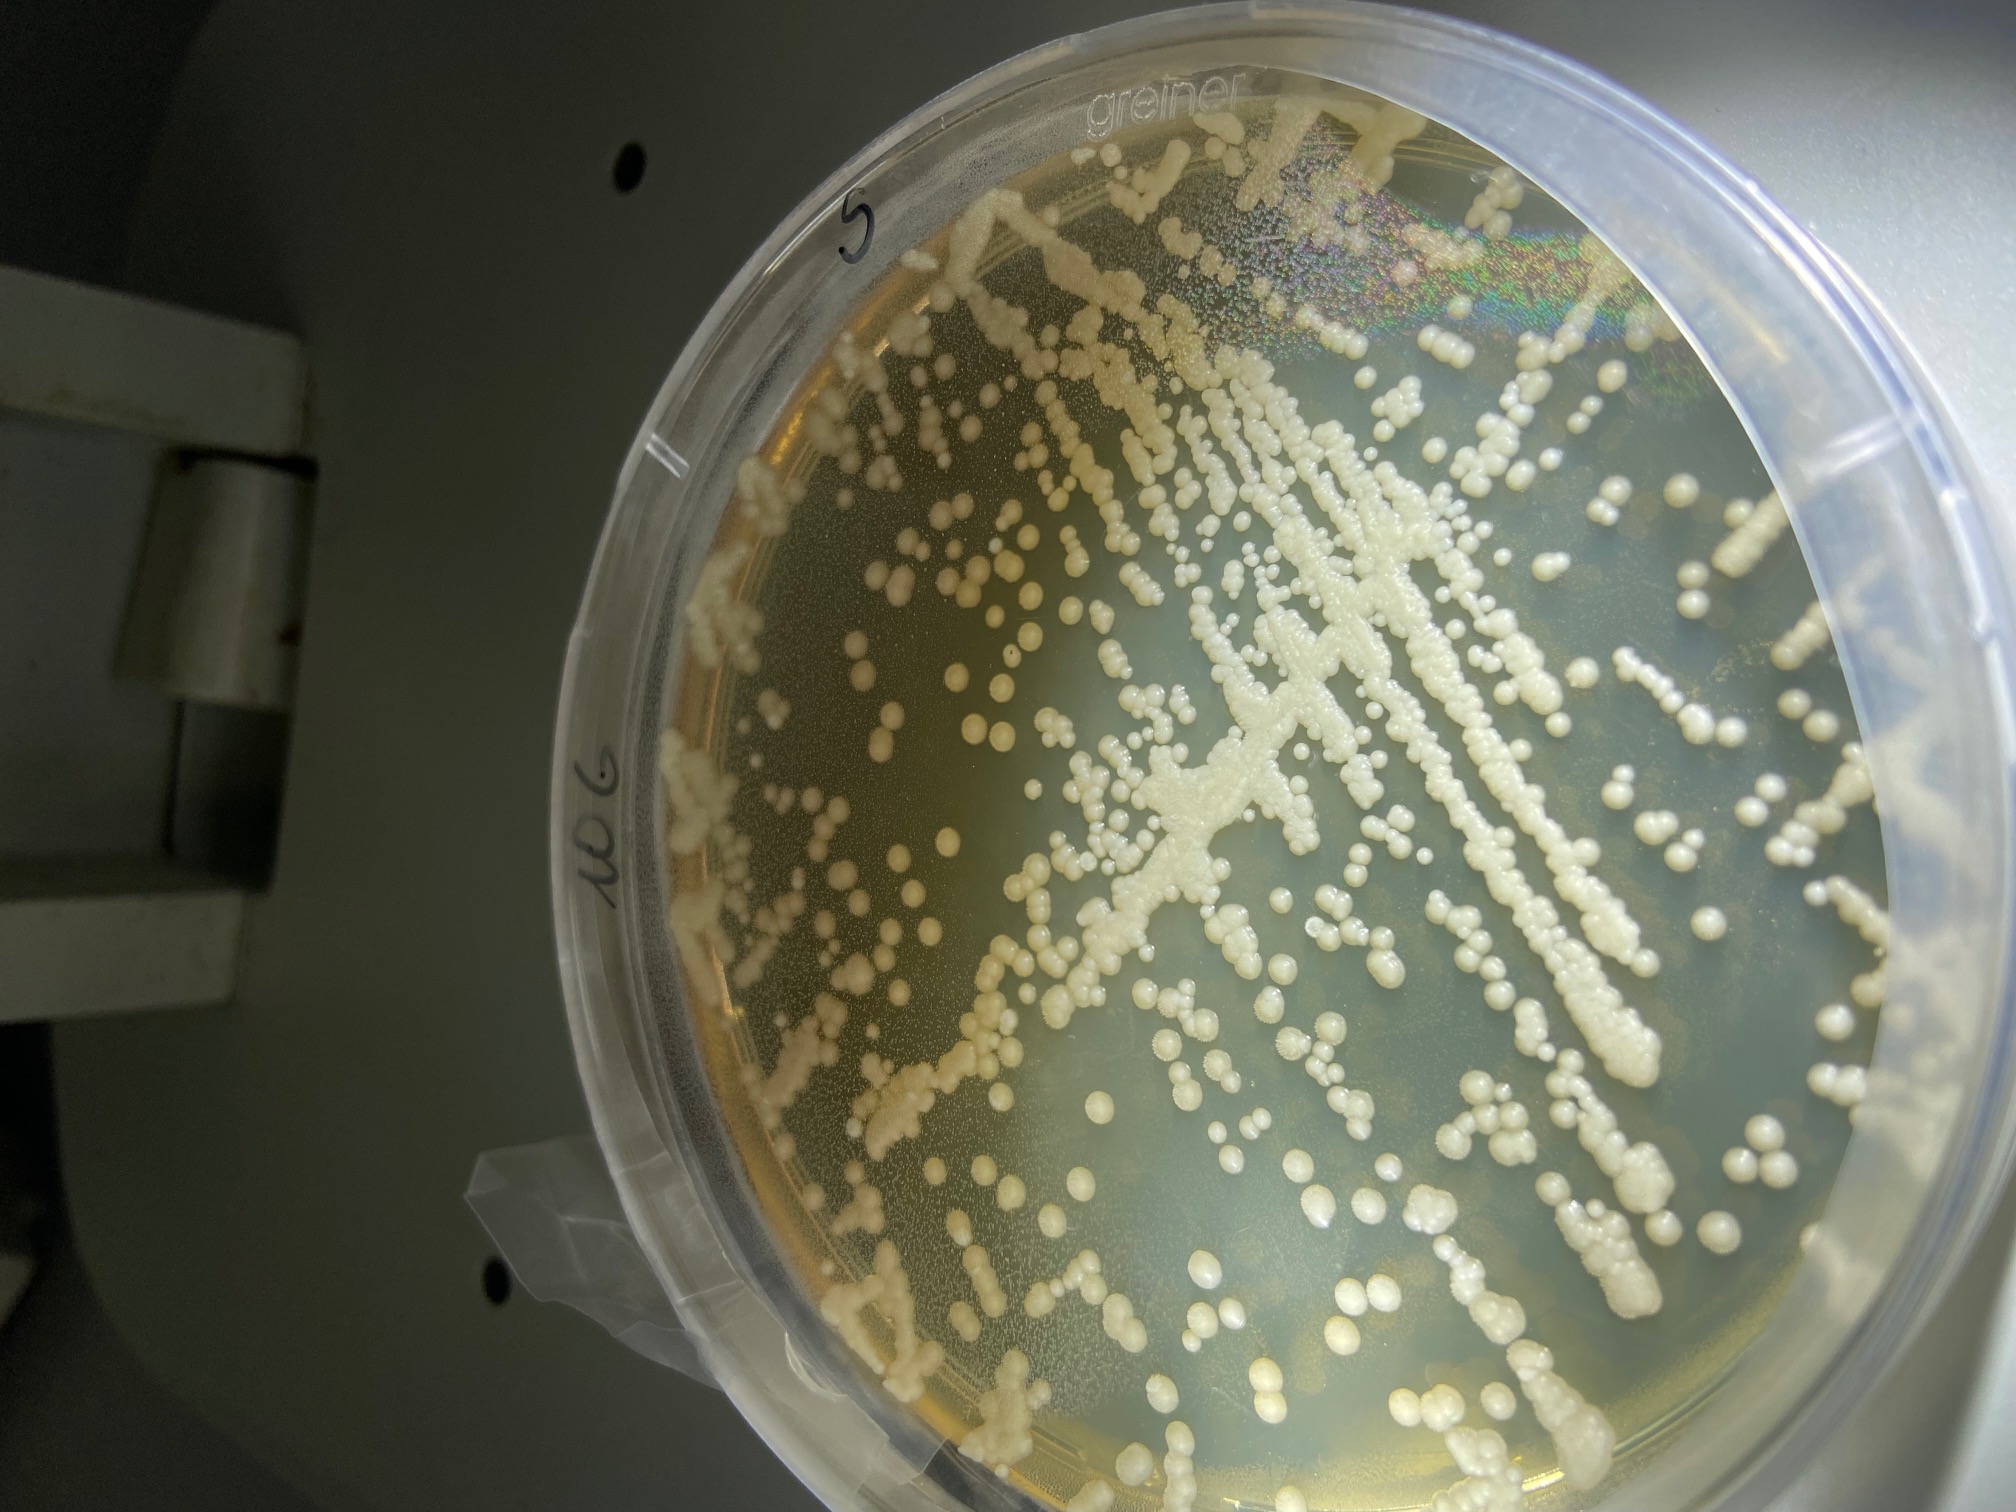
We cultivate oil-degrading microorganisms in the laboratory

Our journey
Even though we are currently moving toward a fossil-free economy, the world is significantly dependent on oil. Machines burn fuels and have leakages, affecting water quality, human health, ecosystems and economy. With the limitations and environmental concerns tied to the currently used solutions, a rising demand emerges for innovative alternatives.
1.
Biotechnology
There are microorganisms that use oil as food. And we have only to create the best conditions for them to fight with oil spills. So, in our lab we are combining those microorganisms with natural support materials like straw and saw dust, as well as simulating different application scenarios. What is great about those microorganisms is that they naturally exist in the Baltic Sea environment, meaning that this technology will not cause secondary pollution.
Our innovation holds the European patent “Method for Petroleum Hydrocarbon Bioremediation Using Fungi” (No. EP3865460), highlighting its novelty and ingenuity.
Production technology consist of few steps:
1
We extract oil-degrading microorganisms from the Baltic Sea environment
2
We cultivate oil-degrading microorganisms in the laboratory
3
We integrate oil degrading microorganisms on hydrophobized straw

In cooperation with the Ministry of Environment of the Republic of Lithuania, Klaipeda State Seaport Authority (Lithuania) and Klaipeda University (Lithuania) our blue biotechnology was tested in real-life conditions at Klaipeda port area.
For this testing, the oil-degrading microorganisms were integrated in a different material as a proof of concept: the agriculture residue – straw, was chosen among different matrixes.
environmentally friendly
using agriculture residue
fast activation
easily adapted to different regions
widely applied at any distances from shore and water depth
2.
InnoAerogel
InnoAerogel, at its core, is an ultralight, super-absorbent derived from recycled paper waste. Breakthrough innovation is the integration of oil-degrading microorganisms into the structure of aerogel that expedites the cleaning of oil spills, the biodegradation process, and so minimizes the environmental impact by solving the problem of disposing of used material.
InnoAerogel’s solution complies with the Sustainable Development Goals of the United Nations and the European Union Policies, encompassing the Circular Economy Action Plan, the Green Deal and Marine Strategy Framework Directive – the Biodiversity Strategy for 2030.

Production technology consist of few steps. Each of them adds new properties to make product best on the market.
1
We take waste paper, mix it with the water to reach uniform distribution
2
We freeze dry it to create extremely high porosity
3
We modify surface to absorb only fuel, but not water
4
We integrate special microorganisms inside the aerogel to make the biodegradation process even faster




Despite the wide application possibilities of aerogel (wastewater treatment from dyes sorbent, insulation material, biomed application etc.), currently we are concentrating on oil spills clean-up and focusing on a shipping and coast guard first.
100%
sustainable
x2
lighter
100%
biodegradable
x2
effective
up to 5
times reusable